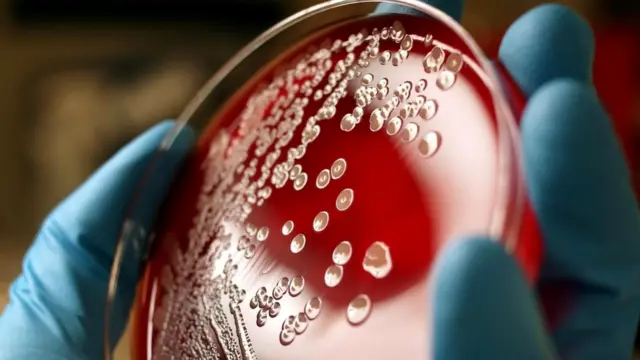
Под каждым ногтем могут жить сотни тысяч бактерий

Кто живет у вас под ногтями и почему важно об этом знать

Автор фото, Getty Images
- Автор, Джейсон Голдман
- Место работы, BBC Future
Мытье рук - основной способ защититься от вредных бактерий. Но заботитесь ли вы о чистоте ногтей - точнее, той области ваших кончиков пальцев, что находится под ногтями? Обозреватель BBC Future выясняет, почему это важно.
Все знают, что мытье рук - это лучшее средство борьбы с распространением бактерий. Во многих странах законодательство обязывает сотрудников сферы общественного питания следить за чистотой рук.
С другой стороны, сколько бы мы ни мыли руки, мы не сможем избавиться от всех бактерий.
Именно из-за невозможности достичь полной стерильности врачи и медсестры при взаимодействии с пациентами так часто надевают перчатки.
Еще столетие назад врачи поняли, что даже после неоднократного мытья рук на них остаются бактерии, которые неизменно проявляются в пробах. Однако причина подобной стойкости обнаружилась лишь в начале 1970-х.
Исследователи выяснили, что руки дольше остаются чистыми, если прикрыть кончики пальцев.
Впрочем, бактериями кишат не столько кончики пальцев, сколько наши ногти.
Под этими тонкими кератиновыми пластинками, по составу схожими с рогами носорога и антилопы, можно найти целую коллекцию бактерий.

Автор фото, Getty Images
Только в конце 1980-х ученые наконец заглянули под ногти и выяснили, кто там живет.
В исследовании, проведенном тремя научными сотрудниками Пенсильванского университета и увидевшем свет в 1988 году, приняло участие 26 взрослых добровольцев.
Все они работали в медицинской школе университета, но не контактировали с пациентами.
Исследователи пришли к выводу, что именно в подногтевом пространстве прячется больше всего бактерий.
На открытых участках ладоней волонтеров жили сотни тысяч бактерий, в то время как примерно то же число можно было найти всего лишь под одним ногтем - под каждым из ногтей!
Под ногтями скапливались те же бактерии, что и на ладони, просто их было намного больше.
Ученые заключили, что пространство между кожей и ногтем - это идеальная среда для размножения и роста микроорганизмов.
Ноготь защищает их от внешних воздействий, а влажность помогает им расти.
В своей работе исследователи учли предыдущие наблюдения относительно того, что при помощи мытья невозможно достигнуть стерильности рук.
В итоге они заключили, что "существенное количество бактерий в подногтевом пространстве свидетельствует о том, что при обычном мытье рук этот участок относительно недоступен для антимикробных средств".
Только вдумайтесь: самые простые и эффективные средства для борьбы с распространением болезней абсолютно бесполезны, когда речь идет о наших ногтях.
В результате был проведен ряд исследований, посвященных изучению микроорганизмов, живущих под ногтями у сотрудников медучреждений, причем не только под натуральными, но и под искусственными и покрытыми лаком ногтями.
Число этих исследований невелико, но их результаты очень востребованы.
Автор фото, Getty Images
Всего через год после исследования Пенсильванского университета в свет вышла работа группы медсестер, которых также заинтересовал этот вопрос.
Они обратили внимание на то, что многие медработники поддаются моде и наращивают ногти, несмотря на то, что их безопасность и практичность остаются под вопросом.
Целью исследователей было выяснить, собирается ли больше бактерий под искусственными ногтями (которые обычно длиннее натуральных и покрыты лаком).
Для этого они пригласили 56 медсестер с обычными и 56 медсестер с искусственными ногтями.
Кроме того, они хотели сравнить, насколько эффективным будет мытье рук в обеих группах.
Авторы научной работы обнаружили, что у медсестер с искусственными ногтями на кончиках пальцев было больше бактерий по сравнению с их коллегами с натуральными ногтями - как до мытья, так и после.
Это не обязательно означает, что от них пациентам передавалось большее количество бактерий - просто у них под ногтями проживала более многочисленная колония микроорганизмов.
Тем не менее был сделан вывод о том, что повышенное число бактерий увеличивает риск распространения болезнетворных организмов.
Схожие исследования, опубликованные в 2000 и 2002 годах, дали практически те же результаты.
Однако к тому времени ученые уже выяснили, что искусственные ногти могут препятствовать тщательному мытью рук и усугублять уже имеющиеся проблемы.
К тому же у медработников с искусственными ногтями чаще рвутся перчатки.
С покрытыми лаком натуральными ногтями возникла другая проблема. В этом случае опасность могли представлять небольшие сколы или трещины как вероятные места скопления бактерий.
В 1993 году медсестры из больницы Джона Хопкинса в Балтиморе исследовали ногти 26 взрослых женщин.
Все они работали в больнице, но не взаимодействовали с пациентами. У всех были короткие ногти. Оценка производилась до нанесения лака и через четыре дня после этого.

Автор фото, Getty Images
Как оказалось, лак на натуральных ногтях не оказывает такого влияния на населенность подногтевого пространства, как это происходит в случае искусственных.
Исследователи заключили, что важно коротко стричь ногти и держать их в чистоте, а покрыты они лаком или нет - не так важно.
Через год было проведено схожее исследование, и вновь выводы остались неизменными.
Да, через четыре дня на покрытых лаком ногтях скопились бактерии, но свеженакрашенные были в этом смысле в полном порядке.
Ежегодно от диареи умирает от двух до трех миллионов человек. Считается, что мытье рук с мылом могло бы спасти примерно миллион из них.
Вероятно, это правда. Но при одном условии: во время этой процедуры нужно уделять особое внимание ногтям и пространству под ними.
А чтобы наверняка обезопасить себя от инфекции, лучше коротко их подстричь.
И напоследок: прежде чем грызть ногти, вспомните о том, что вы только что прочитали.
Прочитать оригинал этой статьи на английском языке можно на сайте BBC Future.


















